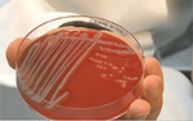

Videos aus der Medizinischen Fakultät der Uni Münster
Ein Film sagt mehr als 1.000 Worte. Auch die Medizinische Fakultät der Universität Münster lässt daher regelmäßig Themen aus Forschung und Lehre "bebildern". So werden auch komplexe Sachverhalte nachvollziehbar.
Diese Seite gibt Ihnen einen Überblick über Filme im Auftrag der Fakultät und solche, die Einrichtungen mit Beteiligung der Fakultät produzieren lassen haben. Tipp: Viele weitere Filme rund um die Universität Münster finden Sie im Videoportal.